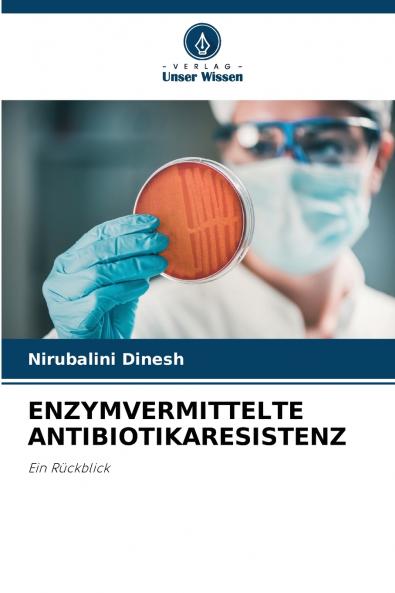
ENZYMVERMITTELTE ANTIBIOTIKARESISTENZ

German
Paperback
₹4773
₹5873
18.73% OFF
(All inclusive*)
Delivery Options
Please enter pincode to check delivery time.
*COD & Shipping Charges may apply on certain items.
Review final details at checkout.
Looking to place a bulk order? SUBMIT DETAILS
Delivery Options
Please enter pincode to check delivery time.
*COD & Shipping Charges may apply on certain items.
Review final details at checkout.
About The Book
Description
Author
Die Antibiotikaresistenz der Erreger von Infektionskrankheiten ist ein weltweites Gesundheitsproblem in Biologie und Medizin. Die Mechanismen der Resistenz gegen antimikrobielle Mittel die zur Behandlung von Infektionskrankheiten eingesetzt werden sind bereits bekannt bevor Antibiotika routinemäßig in der Klinik eingesetzt wurden. Der unbedachte und oft übermäßige Einsatz von Antibiotika hat das Problem jedoch verschärft da sich resistente Bakterienpopulationen auf Kosten der empfindlichen angereichert haben. Das Auftreten von Antibiotikaresistenzen führt zu einer erhöhten Sterblichkeit Morbidität und Behandlungskosten. Obwohl es verschiedene Hinweise auf den Missbrauch von Antibiotika durch Leistungserbringer im Gesundheitswesen nicht ausgebildete Ärzte und Arzneimittelkonsumenten gibt ist das Bewusstsein für die Kontrolle und Prävention von Antibiotikaresistenzen im Gesundheitswesen nach wie vor unzureichend. Ohne dringende Maßnahmen steuern wir auf eine post-antibiotische Ära zu in der gewöhnliche Infektionen und kleinere Verletzungen wieder tödlich sein können. In diesem Buch soll daher ein Überblick über die enzymvermittelte Antibiotikaresistenz und ihre Entstehungsmechanismen gegeben werden die der am besten charakterisierte Mechanismus der Resistenz ist. Außerdem werden Empfehlungen für Maßnahmen zu ihrer Bekämpfung gegeben.
Details
ISBN 13
9786205383360
Publication Date
-23-11-2022
Pages
-60
Weight
-95 grams
Dimensions
-152x229x3.65 mm